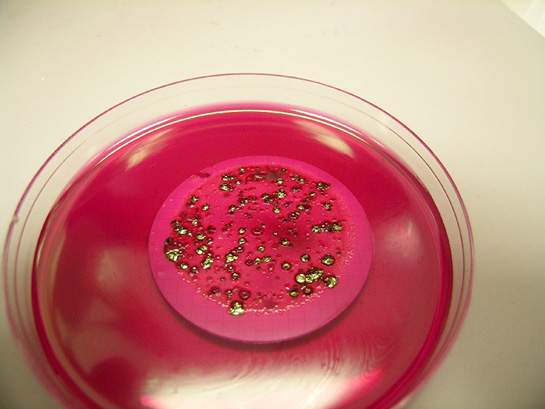

E Coli Bakterisi; Bir bakteri cinsi olan Escherichia coli Avusturyalı bir doktor ve enterobacteriaceae ailesine ait bu bakteri cinsini ilk olarak izole eden Thedor von Escherich (1857-1911) tarafından adlandırılmıştır. Bu bakteri cinsi insanların ve öbür hayvanların bağırsak sistemlerinde yaygın bir biçimde yer almaktadır. Adının okunuşu ve yazılışı zor olduğu için çoğunlukla E.coli olarak belirtilir. E.coli bakterisi vücutta selülozun parçalanmasına ve K vitamininin absorbsiyonuna katkıda bulunmaktadır.
Fakat tüm formları bu kadar faydalı değildir.
İlk olarak 1982 senesinde belirlenen E. coli O157:H7 formu en kötüsüdür. Ve rotoksin ismi verilen çok kuvvetli bir zehir salgılar ve bu zehir insan böbreğinde, beyninde ve bağırsağında yer alan alıcı hücreler ile bağlanarak bu hücreleri öldürür. Bu alıcı hücreler de her insanda bulunmadığı için herkeste aynı etkiyi göstermez. Bu durumun sebebi bazı insanların ve hayvanların E. coli O157:H7 alınması ile fazla bir şekilde hastalanmasına sebep olurken, bazılarına ise bir şey olmamasını açıklar.
E. coli O157:H7 çoğunlukla sığırların mide ve bağırsak kanalında yer alan mutant bir bakteri cinsidir. Sığırların et olarak tüketilen kasları bu bakteri cinsini içermez. Fakat enfekte bir sığırın dışkısı ile yada bağırsakları ile temas etmiş olan ete de bulaşma olasılığı vardır. Stres altında kalan sığırların E. coli barındırmaya daha uygun olduğu düşünülse de E. coli bakterisinin nereden geldiği sorusu henüz yanıt bulamamıştır. Çoğunlukla çiftliklerde beslenen sığırlar, otlanma esnasında henüz tam olarak doymamış iken sürünün yemek olmayan kapalı ortamlara toplanması gibi sebeplerden ötürü strese maruz kalmaktadırlar.
Dar bölgelerde hayatlarını devam etdirdiklerinde ise birbirlerinin üzerine dışkılarının bulaşmama riski yok denilecek kadar az olmaktadır. Bu sebeple de derilerinin üzerinde pislikler, kümecikler şeklinde bulunmaktadır. Kesim zamanında kesimhaneye gönderilen hayvanlar ilk önce bayıltılıp bir taşıma bandına asılmaktadır ve bu taşıma bandının sağa sola hareketi sırasında, kesilecek hayvanın derisinde bulunan pisliklerin daha önceden kesilmiş bir havyanın etinin üzerine gelerek kontamine etme riski vardır. Bazen de kesilen hayvanlar askıdan pis olan yere düşerek yeteri şekilde temizlenmeden tekrar askıya çıkarılabilmektedir.
E. coli ile en çok kontamine olan etler çoğunlukla hamburger etleridir. Çünkü normal olarak satın aldığınız hamburgerin eti belki 100 değişik sığırın etinin karması olabilir ve bu kullanılan etler de tahmin edileceği gibi en iyi kalite etler değildir. Çoğunlukla artık süt vermeyen ve yaşlı hayvanların etidir. Bu hayvanlardan birinin bile eti dahi E. coli taşısa, kullanılan öbür tüm hayvanların etleri de proses sırasında bu etle karışacağından kontamine olur ve böyle büyük hacimlerde üretimlerde, kalite kontrol aşamaları her ne kadar sıkı olsa da atlama riski yer almaktadır. Bu sebeple oldukça sık hamburger kaynaklı E. coli zehirlenmesine dair haberler çok fazla karşımıza çıkmaktadır.
1970’li senelerin sonlarına kadar sebebi tam olarak bilinmeyen bu gizemli hamburger hastalığı artık E.coli zehirlenmesi olarak belirtilmiştir. 1977 senesinde Kanada’da meşhur bir fast food zincirinde satılan hamburgerler rahatsızlıkların oluşmasıyla patlak verdi. Çoğunlukla fazla olan sancılı bir karın ağrısı ve bununla beraber devam eden kanlı ishal hastalığın genel semptomlarıydı. Bazı insanlar önce böbreklerin daha sonra vücuttaki tüm organların fonksiyonlarının sona ermesiyle başlayan ve tedavisi olmayıp ölümcül nitelikte olan hemolitik üremik sendrom sebebiyle yatağa düşüyordu.
Bunlarda İlginizi Çekebilir

Hiç yorum yok:
Yorum Gönder